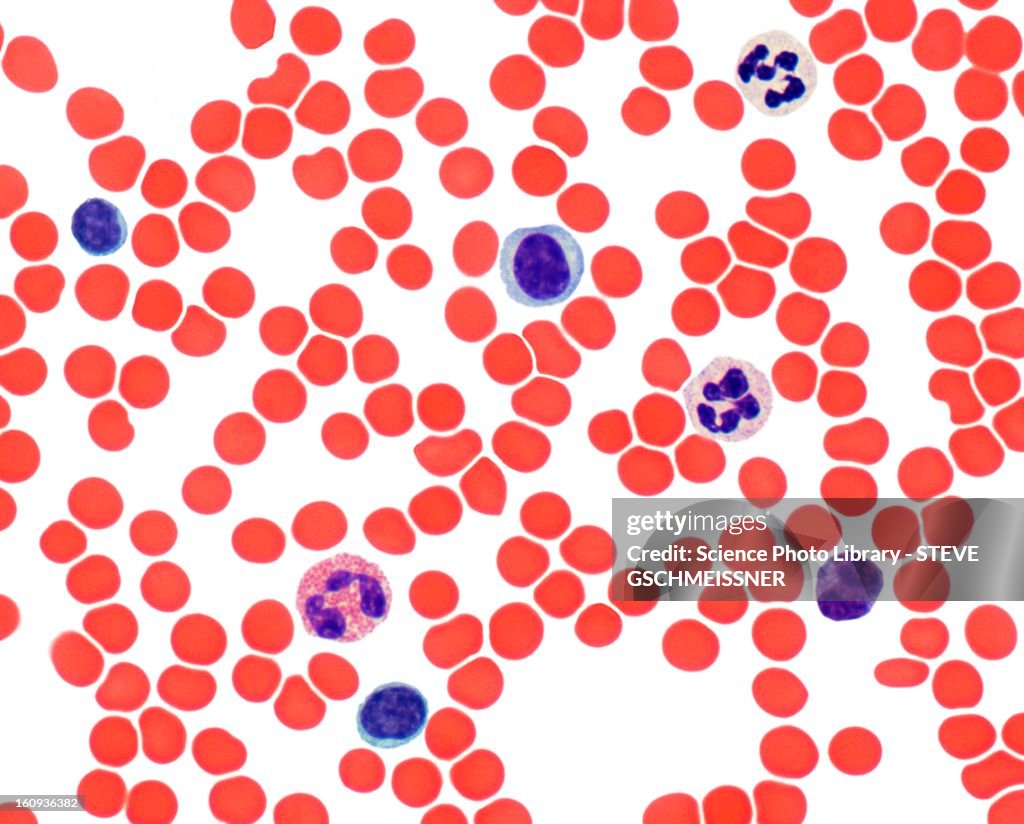

Blood smear, light micrograph - Ilustración de stock
Blood smear. Light micrograph showing normal red and white blood cells. Magnification: x500 when printed at 10 centimetres wide.

COMPRAR LICENCIA
Todas las licencias libres de derechos incluyen derechos de uso mundiales, protección completa y precios sencillos con descuentos por volumen.
AR$ 208.500,00
ARS
Getty ImagesBlood Smear Light Micrograph, Foto de stock Descarga ilustraciones de stock de Blood smear, light micrograph auténticas y de calidad premium de Getty Images. Explora ilustraciones de stock de alta resolución similares en nuestro extenso catálogo visual.Product #:160936382
Descarga ilustraciones de stock de Blood smear, light micrograph auténticas y de calidad premium de Getty Images. Explora ilustraciones de stock de alta resolución similares en nuestro extenso catálogo visual.Product #:160936382
Descarga ilustraciones de stock de Blood smear, light micrograph auténticas y de calidad premium de Getty Images. Explora ilustraciones de stock de alta resolución similares en nuestro extenso catálogo visual.Product #:160936382
Descarga ilustraciones de stock de Blood smear, light micrograph auténticas y de calidad premium de Getty Images. Explora ilustraciones de stock de alta resolución similares en nuestro extenso catálogo visual.Product #:160936382AR$208.500AR$35.500
Getty Images
In stockDETALLES
Creative n.º:
160936382
Tipo de licencia:
Colección:
Brand X Pictures
Tamaño máx. archivo:
4683 x 3769 px (39,65 x 31,91 cm) - 300 dpi - 3 MB
Fecha de subida:
Inf. de autorización:
No se precisa autorización
Categorías:
- Anatomía,
- Asistencia sanitaria y medicina,
- Biología,
- Ciencia,
- Color - Tipo de imagen,
- Célula,
- Grupo grande de objetos,
- Hematología,
- Horizontal,
- Ilustración,
- Ilustración biomédica,
- Imagen generada digitalmente,
- Magnificación,
- Microbiología,
- Micrografía científica,
- Micrografía de luz,
- Producto artístico,
- Sangre,
- Sin personas,
- Órgano interno humano,